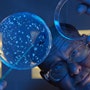
1660604202229 Paulvitennbutton

Figure 2. Demonstration Plant: Facility in Jennings, La.,
uses bagasse and sugar waste to produce ethanol.
Source: Verenium.
|
Expanding the ChoicesThe number and variety of project and product announcements suggest a fast pace of activity in the biofeedstocks and renewables arena. The movement from food-based ethanol to cellulosic ethanol is brisk. Besides the DDCE/University of Tennessee demonstration plant, BP, London, and Verenium, Cambridge, Mass., announced in February a 50/50 joint venture for a commercial-scale plant in Highlands County, Fla., with ground breaking planned in 2010. Ethanol now is being produced from bagasse and sugar waste by Verenium in Jennings, La. (Figure 2), from woody biomass by Range Fuels, in Denver, Colo., and from wheat straw by Iogen in Ottawa, Canada, according to the annual report posted at the RFA website, http://www.ethanolrfa.org. Other feedstocks attract chemical experts and corporate investors, too. Algae promises high supply scale-up potential because of its prolific growth. OriginOil, Los Angeles, says its bioreactor technology speeds algae development; the company hopes to license that technology to customers including chemical and oil companies, and to enter into partnerships with biofuels producers. Archer Daniels Midland (ADM), Decatur, Ill., is collaborating with ConocoPhillips, Houston, to turn corn stover, switchgrass and wood waste into biocrude that can be processed in traditional refineries. In addition, ADM is operating biodiesel production plants in North Dakota and Brazil. There's also plenty of action in products and services to support bio-based production or reduce its cost. For instance, Verenium announced in March a partnership with Alfa Laval, Lund, Sweden, to offer enzymatic degumming services that increase the yields of biodiesel — using Verenium's Purifine PLC enzyme and Alfa Laval's engineering services and equipment. Meanwhile, Rohm and Haas, Philadelphia, (now part of Dow) has introduced a feedstock purification technology that is said to allow biodiesel makers to efficiently convert alternative feedstocks like crude vegetable oils and animal fats. Akzo Nobel Polymer Chemicals, Chicago, and lactic-acid-derivatives supplier Purac, Gorinchem, the Netherlands, reported in January that they've developed additives that will broaden the applications for polylactic acid (PLA) in the growing biopolymer market. The new additives help make PLA more stable and amenable to various processing equipment.
Altering its ApproachDuPont's primary goal only a few years ago was to not add bio-components to its existing portfolio but to find "transformative new products that could only be brought to market using the new biotechnology tools." Biobutanol, now in development with partner BP, reflects that goal — "a new product with superior performance that just happened to be biologically derived and renewably sourced," notes Jan Koninckx, global business director for DuPont BioFuels, a part of DuPont Applied BioSciences. He tells
Chemical Processing DuPont remains interested in biofeedstocks that entail a different approach but is also willing to invest in biofeedstocks that promise to fit well into existing processes. Biobutanol "will likely fit into the existing grain ethanol process infrastructure," he expects; the DDCE joint venture will seek to bolt its technology onto existing grain ethanol assets or will develop new stand-alone facilities. One thing is for sure, says Koninckx: "The development of new biomaterials, biofuels and other Applied BioSciences products and technologies requires an integration of disciplines." DuPont's broad toolkit doesn't negate the need for partnerships with other companies "in this day and age where speed to market is so critical." Koninckx points to Bio-PDO — 1,3 propanediol derived from corn and considered an important building block for bioproducts including polymers. The company partnered with Genencor, Rochester, N.Y., (now a division of Danisco) to develop the catalyst; Bio-PDO is manufactured in the Loudon, Tenn., plant of joint venture DuPont Tate & Lyle Bio Products. DuPont "will always have a door open to potential partnerships that help us move our technologies from lab to market in the most sustainable and cost-effective way," declares Konnickx.
Working Along a Broad FrontDow Chemical also is striving to broadly use renewable resources. The Midland, Mich.-based firm in January announced its latest collaborative agreement to help reduce dependence on traditional oil and gas sources. It aims to jointly develop technology with specialty chemicals company Sud-Chemie, Munich, Germany, to more efficiently and economically convert synthesis gas, derived from biomass as well as coal, into "building block" chemicals. Efforts will focus on catalysts to produce chemicals including alcohols and olefins, the companies say. Dow adds that its enthusiasm for syngas conversion, which is largely understood to yield chemicals and fuels using existing (albeit expensive) technology, is "a promising route for the scale that Dow needs to have an impact." Dow is involved in many other renewables-focused partnerships. For instance, the firm says it's finalizing an agreement with DOE's National Renewable Energy Laboratory, Golden, Colo., to jointly develop and evaluate a biomass conversion process using a "mixed alcohol catalyst" from Dow. The aim is to transform materials like wood wastes and corn leaves into syngas for further conversion into ethanol and other alcohols. Dow is moving ahead on a number of other fronts, including its Renuva brand technology for making soybean-based polyols and its use of glycerin byproduct from biodiesel manufacture for producing Propylene Glycol Renewable and epichlorhydrin. The company is teaming up with Crystalsev/Santelisa Vale in Brazil to make polyethylene from sugar cane. Plans call for a 350,000-metric-ton/yr facility; startup date isn't firm. The worldwide economic situation isn't calling into question the company's push into renewables but does affect "how fast you can move," says Steve Tuttle, global business director for Dow BioSciences. Today's tough climate actually proves the value of partnerships that "help leverage external expertise," he adds. Dow, like other companies, says it continues to scrutinize each renewable-resources business prospect from a number of perspectives, including the availability and scale-up potential of appropriate feedstocks, the market for intermediate and end products, and compatibility of feedstocks and products with infrastructure and processes. Prospects generally keep improving. Innovation "continues to expand, not just in a linear fashion, because as you learn and advance technology, it becomes exponential," explains Tuttle.
Coming TogetherAs knowledge deepens, the distinctions between work on biofuels and biofeedstocks are becoming less sharp, Tuttle says. "A molecule doesn't know whether it's going to be used for fuel or chemicals." A well-positioned company understands "the fuel/chemistry interface." Research and development that benefits both the fuel and chemistry sides "has dual market opportunities." Dow also gains from its expertise in catalysis because it's "a big enabler" for work in such high-priority areas as algae, biocrude, cellulosics and syngas, notes Bob Maughon, senior R&D director for the hydrocarbons and energy business. The potential to integrate diverse bio-focused technologies also captures the imagination at DuPont, and undoubtedly at other chemical companies. The collection of operations within DuPont's Applied BioSciences business and its Bio Materials group presents such opportunities for convergence, notes Koninckx. "You never know if these two businesses may connect at some point in the future," he says. "Our lead scientist often talks about an integrated biorefinery that produces cellulosic ethanol, grain ethanol, biobutanol and biomaterials. It is possible in the future."
Sidebar: Mandate Promises Economic Boost The U.S. Renewable Fuels Standard (RFS) sets requirements for blending advanced biofuels — not ethanol derived from corn starch — into gasoline and other transportation fuels. The RFS begins at 0.6 billion gal/yr in 2009 and reaches 21 billion gal/yr in 2022. Such advanced biofuels are expected to reduce lifecycle greenhouse-gas emissions by at least 50% from baseline levels. They also promise to spur significant investments and new jobs, according to "U.S. Economic Impact of Advanced Biofuels Production: Perspectives to 2030" by Bio Economic Research Associates, Cambridge, Mass. That report, released in February 2009 by the Biotechnology Industry Organization, predicts: • Investments in advanced biofuels processing plants will reach $3.2 billion in 2012 and $12.2 billion by 2022.• Direct economic output from the advanced biofuels industry, including capital investments, R&D, technology royalties, processing operations, feedstock production, and biofuels distribution will rise from $5.5 billion in 2012 to $37 billion by 2022. • Direct job creation from advanced biofuels production could reach 29,000 by 2012 and 190,000 by 2022. This will include jobs for operators and technicians.